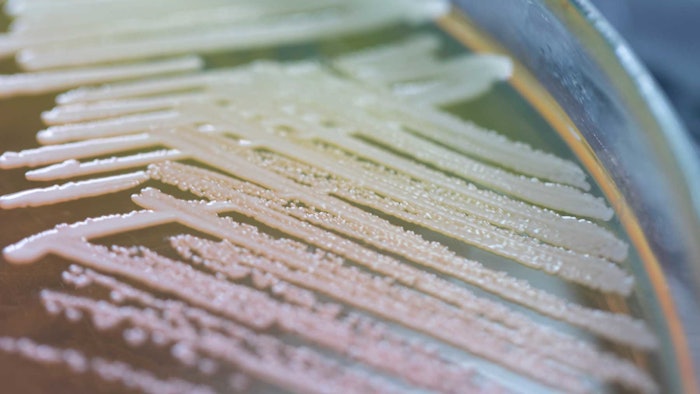

Ginkgo Bioworks and Sumitomo Chemical Co., Ltd., announced a collaboration to target and ferment an unspecified molecule to offer a more sustainable alternative to the personal care and cosmetic industries.
See archived: Cronos Group and Ginkgo Bioworks to Accelerate CBG Production
According to the companies, this molecule is envisioned to augment or replace an ingredient that is currently gathered from animal sources—a process that is not sustainable and also unappealing to many consumers—by engineering a strain that will produce the targeted ingredient through fermentation.
This project is in addition to the companies' existing collaboration, which began in 2021 and focuses on the bio-based production of selected molecules for the broad Sumitomo Chemical portfolio; here, offerings range from personal care and cosmetics to agriculture and pharma, and from chemicals to industrial products and more.
See related: Bioferments in Beauty; Infusing Antioxidant and Microbiome Benefits into Skin
"The cosmetics industry is demanding more sustainable and cost-competitive beauty and personal care products, as are many others we serve, and we see tremendous potential in synthetic biology's ability to make this possible at a commercial scale," said Hiroshi Ueda, executive vice president of Sumitomo Chemical.
"We're encouraged by the progress of our ongoing first project with Ginkgo, and we believe it's clear from how well our teams collaborate that we will also be able to find success within additional product areas ... Through this project, we aim to build our own capability on fermentation production with [the] active involvement of our new organization SynBio Hub."
Patrick Boyle, head of codebase for Ginkgo, added, "Not only is this project a natural fit for Ginkgo's platform, but it provides the perfect opportunity to leverage and showcase our growing codebase. ... Ginkgo has prior experience developing a precursor molecule to the one Sumitomo Chemical is currently targeting. The data and experience Ginkgo has on this precursor molecule has significantly accelerated our current program with Sumitomo Chemical, possibly saving Sumitomo Chemical multiple years off its development timeline."
Follow us as additional details unfold.